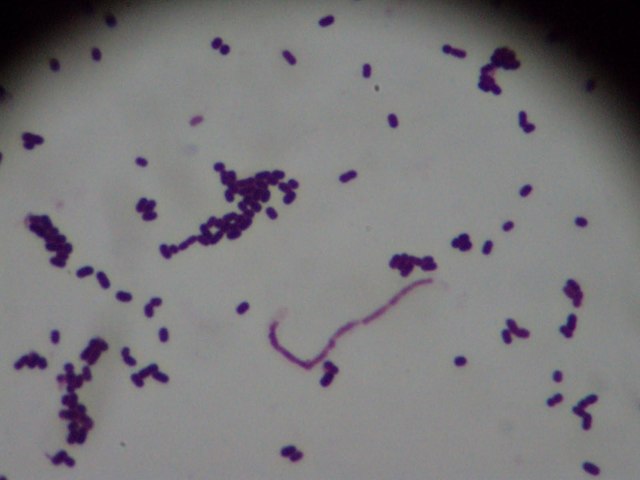
Bacterias en la leche

-
Fabricación de cerveza en la antigua Babilonia
-
Asirios prepararon vino
-
Judíos usaron la sal del Mar Muerto en la conservación de diversos alimentos.
-
Embutidos fermentados fueron preparados y consumidos por los antiguos babilonios y por los habitantes de la antigua China.
-
Romanos destacaron en la conservación de otras carnes diferentes a la de vacuno.
-
Apareció el ahumado de la carne como procedimiento para conservarlas, la fabricación de quesos y vinos.
-
La intoxicación por cornezuelo de centeno (producida por Claviceps purpurea, un hongo que crece en el centeno y en otros granos de cereales) causo muchas muertes.
-
En Augsburgo se publicó una ordenanza obligatoria relativa al sacrificio de las reses y a la inspección de las carnes en mataderos públicos.
-
Kircher demostró la presencia de bacterias en la leche
-
Leeuwenhoek fue quien primero observó las células de las levaduras.
-
D. Papin y G. Leibniz conservación de los alimentos por medio del calor a los principios del siglo XVIII.
-
Spallanzani demostró que el caldo de carne de vaca sometido a ebullción durante una hora y que había sido cerrado, permanecía estéril y no se corrompía.
-
Scheele identifico el acido láctico como el principal acido de la leche agria
-
Un químico sueco puso en practica el enlatado del vinagre.
-
En Francia, Appert patentó la conservación de los alimentos mediante enlatado.
-
Donkin Hall y Gamble introdujeron la práctica de la incubación de los alimentos enlatados después de su tratamiento
-
El poeta alemán Justinus Karner describió la <intoxicación por embutidos> (que con tada la probabilidad era botulismo) y su elevada tasa de mortalidad
-
Fue concedida una patente de los EE UU a T. Kanset y a E. Dagget para conservar alimentos en botes de hojalata.
-
En Inglaterra, se concendió una patente a Newton para fabricar la leche condensada.
-
Latour descubrió la existencia de las levaduras.
-
Winslow fue el primero en enlatar el maíz separado del carozo
-
Schwann demostró que las infusiones sometidas a la acción del calor permanecían estériles en presencia de aire, el cual introducía en la infusión haciéndolo pasar a través de serpentines de alambique calentados.
-
L.A Fastier le fue concedida a una patente francesa para utilizar una solución de salmuera con el fin de elevar la tempertura de ebullición del agua.
-
Kircher examino el jugo de remolacha viscoso y descubrió microorganismos que forman mucílago cuando crecían en soluciones de sacarosa.
-
Se enlataron por primera vez pescado y fruta.
-
S. Goldner y J. Wertheimer obtuvieron patentes británicas de salmuera basadas en el método de Fastier.
-
En Inglaterra, se concedió una patente a H. Benjamin para congelar alimentos por inmersión en una salmuera de hielo y sal
-
En Maine, I. Winslow fue quien primero intentó la esterilización mediante vapor de agua.
-
R. Chevalier- Appert obtuvo una patente para esterilizar alimentos al autoclave.
-
Pasteur inició sus investigaciones en el vino. El calentamiento para eliminar los microorganismos indeseables se empezó a emplear a escala comercial en 1867-1868.
-
John Snow identificó el agua de bebida como principal fuente de
difusión del cólera. -
En Inglaterra, Grimwade fue quien primero fabrico la leche en polvo
-
En los Estados Unidos, le fue concedida una patente a Gail Borden para fabricar leche condensada no azucarada.
-
W. Taylor de Penrith, Inglaterra, incriminó a leche como transmisora de fiebre tifoidea.
-
La Real Orden aprueba el Reglamento de Inspección de Carnes que contemplaba las funciones y pautas de actuación de los llamados inspectores de carnes y establecía la obligatoriedad de la existencia de mataderos en aquellos municipios por encima de 2000 habitantes
-
I.salomon introdujo el uso de las soluciones de salmuera en Estados Unidos.
-
En los Estados Unidos, se inició a escala comercial la congelación artificial de pescado.
-
Martin adelantó la teoría de que la maduración del queso era parecida al as fermentaciones alcohólica, láctica y butírica.
-
Francesco Selmi anticipó su teoría de la intoxicación por ptomaínas para explicar la enfermedad contraída por la ingestión de determinados alimentos.
-
Gayon realizó el primer estudio documentado sobre la alteración microbiana de los huevos.
-
Se inició el primer uso extensivo del hielo en el transporte de carne por vía marítima. Se pusieron en uso las calderas de vapor a presión o autoclaves.
-
Tyndall observo que las bacterias existentes en las materias de descomposición eran achacables al aire, a las propias materias, o a los envases
-
Cienkowsky informó acerca del primer estudio microbiológico de los mucílagos del azúcar y aisló en ellos Leuconostoc mesentero
-
En Alemania se inició la pasteurización de la leche.
-
Krykowitsch fue quien primero observó el efecto letal del ozono sobre las bacterias causantes de alteraciones.
-
La Real Orden de 8 de febrero de 1885 derogó las competencias de la figura de los “veedores” en favor de los veterinarios al servicio de los municipios, que eran reconocidos como los únicos técnicos idóneos para inspeccionar las reses con destino a los mataderos, así como los embutidos.
-
Foster fue quien primero desmostró la capacidad de los cultivos puros de bacterias para crecer a 0°C.
-
La tindalización es un método de esterilización mediante calentamiento discontinuo (por lo general de alimentos), que debe su nombre a John Tyndall.
-
Gaertner describió, por primera vez, una bacteria capaz de provocar una toxiinfección alimentaria y que después se identificó como la Salmonella
-
Van Ermengem identificó el Clostridium botulinum como agente causal del botulismo.
-
Organización Internacional para la Agricultura y la Alimentación (FAO), fundada tras las Conferencias de Naciones Unidas para la
alimentación y la agricultura, celebradas en Virginia
(1943) y Quebec (1945), que fija inicialmente su sede en
Washington para trasladarla definitivamente a Roma, en
1951. Esta organización tendrá un papel preponderante en
la regularización y armonización de las legislaciones
relacionadas con la salubridad de los alimentos. -
Creada tras convocar la recién nacida ONU, una Conferencia Internacional de Sanidad, que adopta el proyecto de constitución de la OMS, con sede en Ginebra. Su principal misión es promover una mejora sanitaria en todo el mundo.
-
Nace con el objetivo de desarrollar sistemas que proporcionen un alto nivel de garantías sobre la seguridad de los alimentos y de sustituir los sistemas de control de calidad de la época basados en el estudio del producto final que no aportaban demasiada seguridad.
-
Este evento introduce el organismo Escherichia coli en la conciencia pública. El brote, que se remonta a la carne de hamburguesa mal cocida que contiene E. coliO157: H7 servida por la cadena de comida rápida, enferma a más de 600 personas en cuatro estados del oeste. Cuatro niños mueren de síndrome urémico hemolítico (HUS).
-
En respuesta al brote de E. coli 0157: H7, se fundaron varias iniciativas gubernamentales para mejorar la inteligencia de la inocuidad alimentaria, incluidas PulseNet, FoodNet y NARMS.
-
E. coli 0157: H7 se identifica en muestras de heces de personas con HUS que habían bebido el jugo no pasteurizado de la marca Odwalla. Los productos se habían distribuido en varios estados del oeste y Columbia Británica.
-
La Organización Internacional de Normalización (ISO) promulga ISO 22000 , que aborda la gestión de la inocuidad de los alimentos para ayudar a las instalaciones a identificar y controlar los riesgos de seguridad.
-
Una cepa mortal de E. coli mata a más de 40 y enferma a más de 4.000 en Alemania y otras partes de Europa. El 10 de junio, las autoridades alemanas declararon que la evidencia epidemiológica y de la cadena alimentaria descubrió que el brote de semilla fue el vehículo del brote.
-
La USDA FSIS anunció que comenzando 2013 se requerirá que los productores retengan cargamentos de carne de res cruda no intacta y todos los productos listos para consumir productos que contengan carne y aves de corral hasta que se aprueben las pruebas del USDA para los adulterantes transmitidos por los alimentos. No se permitirá que los productos ingresen al mercado hasta que sean negativos para la E. coli productora de la toxina Shiga.
Want to make a timeline like this?
Use Timetoast to turn dates, events, milestones, and phases into a clear visual timeline you can build and share. Timetoast is a timeline maker for work, school, research, and stories.